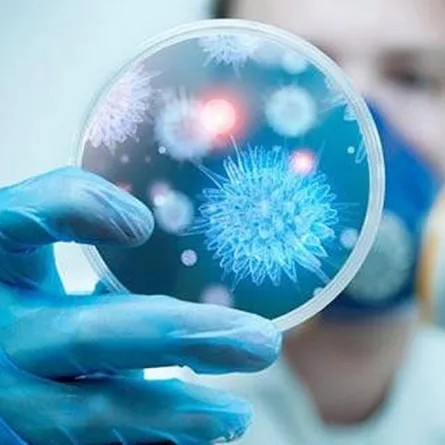
وكيل وزارة الصحة السعودية يحذر من «كورونا»

أكد الوكيل المساعد للصحة الوقائية في وزارة الصحة السعودية، الدكتور عبدالله عسيري، على أن الحالات الحرجة في المملكة العربية السعودية لا تزال قليلة وزيادة عدد حالات فيروس "كورونا" اليومي متوقع بسبب سرعة انتقال المتحور "أوميكرون".
وأشار الدكتور عسيري، إلى أن الوضع الوبائي يشهد زيادة في أعداد الحالات على مستوى العالم، لافتاً في ذات الوقت إلى أن اللقاحات تقلل من ضرر الفيروس بغض النظر عن متحوراته.
اللقاحات تقلل العدوى
وتابع وكيل وزارة الصحة، خلال حواره على قناة "السعودية"، أن اللقاحات تقلل احتمالات العدوى وتمنع المرض الشديد وحدوث وفيات، وتحقق ذلك في مواجهة المتحورات السابقة قبل متحور "دلتا"، موضحًا، أن الفيروس تعلم كيفية تخطي بعض حواجز المناعة واستعاد قدرته على الانتقال مثل متحور "دلتا"، لكن قدرة اللقاحات على منع المرض الشديد مستمرة وتقليل ضراوة المرض والحاجة إلى الرعاية الصحية.
د. عبدالله عسيري - الوكيل المساعد للصحة الوقائية في وزارة الصحة: الحالات الحرجة لا تزال قليلة، وزيادة عدد حالات فيروس كورونا اليومي متوقع بسبب سرعة انتقال المتحور أوميكرون.@K_Alsuliman@assiriama#في_العلن#قناة_السعودية pic.twitter.com/b1Ldgnf3P6
— قناة السعودية (@saudiatv) January 23, 2022
وأوضح، أن الوضع العام للجائحة في المملكة مطمئن، خاصة أن الحالات الحرجة لا تزال قليلة حتى مع زيادة حالات الإصابة بـ"كورونا".
متحور "أوميكرون"
وأضاف، أن متحور "أوميكرون"، والذي بات السلالة الوحيدة الموجودة في المملكة وجميع الدول تقريبًا، يتركز نشاطه في الجزء العلوي من الجهاز التنفسي، إلا أنه قد يصل إلى الرئتين، ولكن لدى أعداد أقل من المصابين مقارنة بغيره من المتحورات، وفي فئة غير المحصنين بصورة أكبر، مقارنة بالفئات الأخرى، مشيرًا، إلى أنه تحول إلى "فيروس زكام" أكثر من كونه فيروساً يصيب الأجزاء السفلية من الجهاز التنفسي.
وأشار الدكتور عسيري، إلى أن هدوء الأمور على مستوى الجائحة مقترن بالوصول إلى حالة توازن بين أعداد الإصابات الجديدة والمناعة المجتمعية.
وفي وقت سابق أكد وكيل وزارة الصحة المساعد للصحة الوقائية، الدكتور عبدالله عسيري، على أن اللقاح المضاد لفيروس "كورونا" لا يؤثر على الخصوبة نهائيًا، ولا يوجد أي رابط بين اللقاح والخصوبة.
وأضاف، أن المناعة الطبيعية أفضل من المناعة المكتسبة، لكن في بعض الأحيان تكون المناعة الناتجة عن اللقاح أفضل، والاعتماد على المناعة الطبيعية مع "كورونا" مغامرة لا ننصح بها.



 Google News
Google News